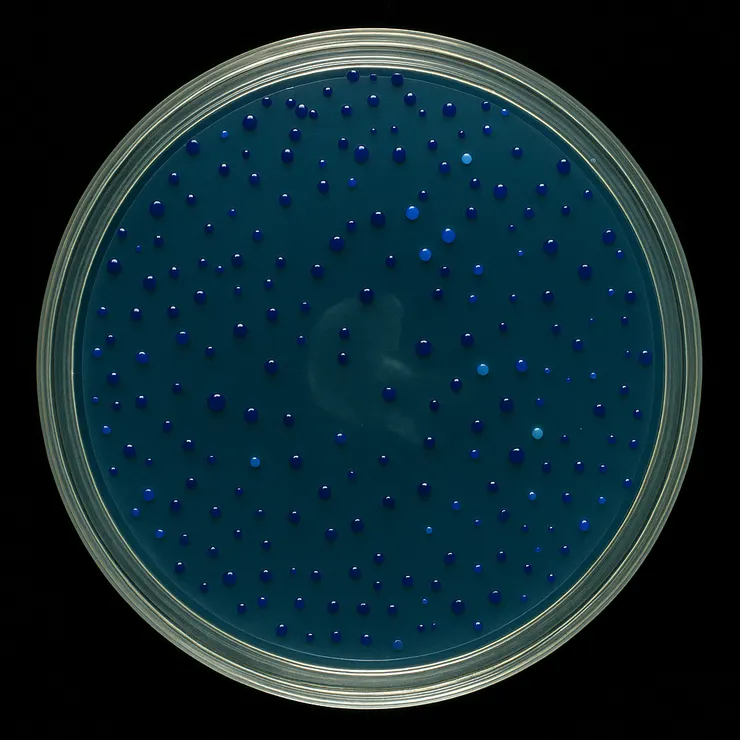
深藍測試示意圖。圖片作者：ChatGPT

在分子生物學的實驗中,大家幾乎都用過「藍白篩選法(blue-white selection)」。利用破壞完整的LacZ酵素影響菌落顯色的原理,它幫助我們辨識哪個菌落帶有成功插入目標 DNA的質體(plasmid)。白色表示有插入,藍色則是失敗。這招簡單又實用,幫助大家無痛篩選(雖然看到整片藍的會很心痛...)。
我進行了不知道多少次的藍白篩,可從沒想過,有一天這個技術會被倒過來用。
2025 年發表在《Science》的一篇研究中,來自牛津大學與其他研究機構的科學家們,意外地讓這個大家熟悉得不能再熟悉的技術「逆轉出道」。
他們的研究對象是植物病原菌丁香假單胞菌(Pseudomonas syringae),它會感染番茄、豆科等多種作物。在過去的研究中,科學家發現這種細菌能透過分泌某種神祕小分子來抑制植物的 β-半乳糖苷酶(BGAL1),從而避開植物的免疫辨識。原本植物的 β-半乳糖苷酶能藉由把細菌鞭毛上的糖鏈切開來釋放免疫訊號,讓植物知道有人入侵了;但是,當這個神秘的小分子存在時,β-半乳糖苷酶失去功能,植物就什麼都不知道了。也就是說,細菌用某種方式「靜音」了免疫警報器。
但這個小分子是什麼?要怎麼找到它?
這時候,藍白篩出場了,不過他們把它整個反過來用:
由於植物受到抑制的酵素是β-半乳糖苷酶,與大腸桿菌的LacZ 酶視同功的酵素,所以讓研究團隊想到,為何不利用做到都不想做的藍白篩來當作篩選系統呢?
首先,他們讓丁香假單胞菌表現來自大腸桿菌的 LacZ 酶,並加入 X-gal 這種會讓菌落變藍的受質。
正常情況下,這個菌自己會產生抑制物(神秘小分子),讓 LacZ 表現下降,所以菌落的顏色只會是淡淡的藍色。但是,如果任何牽涉到分解β-半乳糖苷酶的基因發生突變,細菌就不能產生抑制物,LacZ 就沒有被抑制,於是菌落的顏色反而會變得「超藍」!
深藍測試示意圖。圖片作者:ChatGPT
接下來,他們為這個丁香假單胞菌進行大規模轉位子突變,然後用「變深藍」當作指標,一步步篩選出那些「無法抑制 LacZ 的突變菌」,最終找到了一組基因。
為了確認這些基因的確與那個神秘小分子的合成有關,研究團隊將它們全部刪除。結果發現,刪除後菌落就變深藍了--這意味著細菌不再能產生神秘小分子,無法抑制 LacZ 活性。
相反的,如果把這些基因放回去缺少它們的突變株或大腸桿菌中,都可以讓細菌恢復抑制植物免疫系統的能力。如此一來,就證實了這些基因們的確與神秘小分子的生合成有關。也就是說,這些基因正是那個神祕小分子的製造機。
這個神秘小分子後來被命名為 glycosyrin(意為與糖有關的抑制劑,glyco-(糖) + -syrin,靈感來自 “syringe”),所以與合成它有關的基因們,就被命名為「gsn」了。(是不是跟每個有小孩在念書的家長都被叫做「XX的爸/媽」很像啊?)gsn們包含了 gsnA-E 五個基因,其中ABC三個直接參與合成glycosyrin,另外還有病原性主控因子 hrpR/S, hrpL 與 rhpS 負責控制 gsn 們的轉錄。
研究團隊使用冷凍電子顯微鏡(cryo-EM)解析發現,glycosyrin 是一個帶有水合醛基與五環的亞胺糖(iminosugar),長得跟半乳糖很像。
他們發現,glycosyrin 會用它的氮原子與植物的 β-半乳糖苷酶或細菌的 LacZ 的活性位址進行互動,效果比過去已知的亞胺糖抑制劑(如 1-deoxy-galactonojirimycin)更好。不過,除了植物的 β-半乳糖苷酶以外,其他的植物醣苷酶(例如 β-半乳糖苷酶與 β-葡萄糖苷酶)也會被它抑制。
glycosyrin 是怎麼合成的?研究團隊發現,丁香假單胞菌以PRA(5-phosphoribosyl-1-amine,嘌呤合成路徑的中間產物)為原料,透過GsnB、GsnC、GsnA的合作,產生 glycosyrin。
這個研究最令人讚嘆的地方,並不只是在發現了細菌的 glycosyrin這件事而已,而是他們的巧思!將一個看似「老掉牙」的分子生物技術倒過來用,幫助他們篩選出目標基因。尋常實驗室裡用來挑選重組菌的藍白篩,透過他們的創新想法,搖身一變成了找出病原菌化學武器的探照燈。
這提醒我們一件重要的事:技術不只會用,還要能轉用、創用、活用。
看了這篇論文,下次做實驗時,肯定會用不同角度去看許多實驗室的常規實驗──也許下一個科學靈感,就藏在那裡。
參考文獻:
Sanguankiattichai, N., Chandrasekar, B., Sheng, Y., Hardenbrook, N., Tabak, W. W. A., Drapal, M., … & van der Hoorn, R. A. L. (2025). Bacterial pathogen deploys the iminosugar glycosyrin to manipulate plant glycobiology. Science, 388(6691), 297–303. https://doi.org/10.1126/science.adp2433


























